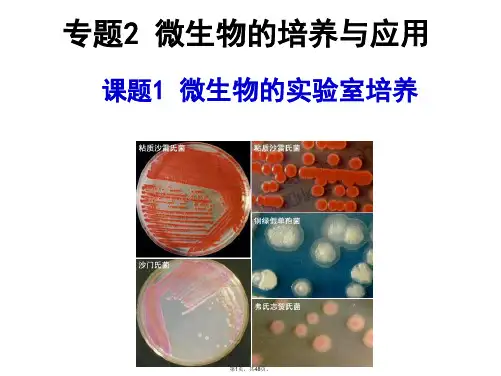

实验动物微生物学分类及控制共75页文档
- 格式:ppt
- 大小:6.35 MB
- 文档页数:75

微生物学实验实验一一、目的要求二、基本原理➢➢➢三、实验材料每组同学需要准备以下材料(2人/组):●●●●●●●●●●●●●●四、实验内容(一)、培养基的配制:注意:标签用铅笔书写,以防高温灭菌时蒸汽模糊字迹。
操作图示:四、实验内容培养基配方:1.配制肉汤斜面培养基50 mL 2.配制麦芽汁斜面培养基3.注意事项:◆◆◆◆(二)培养基灭菌四、实验内容(三)包扎1.培养皿:2.吸管:3.三角玻扒:五、实验报告思考题:◆◆◆◆◆◆◆◆实验二一、目的要求➢➢二、基本原理三、实验材料1.各组所需的物品●●●●2.注意事项:①②①②③④四、实验内容1.微生物的斜面接种技术:斜面接种的操作方法:转下页接种菌名及接种划线方式、接种工具:细菌:霉菌:酵母菌:图2-1 各种无菌操作接种技术示意图图2-2 穿刺接种操作过程示意图2.生物的培养技术——培养箱恒温培养法3. 为下次实验准备平板培养基:注意:标签用铅笔书写,以防高温灭菌时蒸汽模糊字迹。
培养基配方:(1)配制肉汤平板培养基100 mL(2)配制麦芽汁平板培养基配制好的培养基进行灭菌!五、实验报告1.观察记录实验结果:微生物琼脂斜面上的生长状况。
2.思考题:◆◆实验三一、目的要求●●二、基本原理三、实验材料1、各组所需物品:•••••2、平板的制备:四、实验内容1. 平板混合分离法:大肠杆菌,枯草杆菌,单球菌(3皿)图3-1 混合倒平板操作法示意图四、实验内容2. 平板划线分离法:(3皿)图3-2 平板划线分离操作法示意图图3-3 平板划线菌落分离效果图四、实验内容3. 平板涂布分离法(3皿):图3-4 涂布平板操作法示意图四、实验内容4. 平板点殖:黑曲霉,黄曲霉,根霉(3皿)四、实验内容5. 生物的培养技术:培养箱恒温培养法➢➢五、实验报告1、观察记录实验结果:微生物的菌落特征注:菌落特征描写方法参考如下:五、实验报告2、思考题:实验四一、目的要求二、基本原理转下页二、基本原理三、实验材料1. 菌种:2. 每组制片用具:3. 染色剂1套:四、实验内容四、实验内容3.细菌、酵母菌、霉菌的制片技术及个体形态观察:●●●图4-10 涂片制备过程四、实验内容4 注意事项:●●●●。




微生物实验用菌种管理规程(ISO13485-2016/YYT0287-2017)1.0目的规范微生物学检定用菌种的管理,最大限度降低变异率,确保菌种的溯源性与稳定性,从而确保微生物学检验结果的准确可靠。
2.0适用范围适用于微生物实验用菌种管理,包括菌种的申购、传代、使用及销毁等。
3.0引用/参考文件ChP2015实用药品微生物检验检测技术指南4.0职责质量控制实验室负责菌种的申购、传代、使用、销毁等工作,QA负责监控和参与OOS调查。
5.0程序5.1术语和定义5.1.1标准菌株由中国药品生物制品检定所医学微生物菌种保藏管理中心或者其他经认可的机构提供的冷冻干燥菌。
5.1.2传代菌株用标准菌种制备的采用特定保存方法长期固定保存的菌种,用于传代及制备工作用菌种,3代后的传代菌株在需要时可以作为工作菌株使用。
5.1.3工作菌株用标准菌种或传代用菌种接种至普通琼脂斜面培养后,作为日常工作使用的菌种。
5.1.4菌种的代将菌种接种至一新鲜培养基上或培养基内,每萌发一次即称为一代,从菌种保藏中心获得的冷冻干燥菌种为第0代。
5.2菌种来源5.2.1标准菌株由中国药品生物制品检定所医学菌种保藏中心(CMCC)或者其他经认可的机构提供的冷冻干燥菌种。
5.2.2质量控制实验室涉及到的菌种种类、代码、保存方法及保存条件如下。
菌种名称菌种代码保存方法保存温度保存期限TSA斜面2~8℃1个月金黄色葡萄球菌CMCC(B)26003冷冻干燥管-20℃1年TSA斜面2~8℃1个月铜绿假单胞菌CMCC(B)10104冷冻干燥管-20℃1年TSA斜面2~8℃1个月枯草芽孢杆菌CMCC(B)63501冷冻干燥管-20℃1年SDA斜面2~8℃3个月白色念珠菌CMCC(F)98001冷冻干燥管-20℃1年SDA斜面2~8℃3个月黑曲霉菌CMCC(F)98003冷冻干燥管-20℃1年TSA斜面2~8℃1个月生孢梭菌CMCC(B)64941冷冻干燥管-20℃1年5.3菌种的申购、验收、保存5.3.1菌种的申购5.3.1.1微生物室QC依据菌种的库存及菌种的使用情况,提出采购申请,申请需明确菌种的名称,标准编号以及申购数量等信息。




教学实验动物人畜共患病的防控措施韩庆功;崔艳红;陈金山【摘要】为防止实验动物将一些共患疾病传染给人,介绍了猪、禽类、反刍动物、犬猫小动物、鼠与人常见共患病的种类,分析了实验动物与人共患病发生的因素,从加强实验及实训基地建设、制定切实可行的操作规范流程、加强实验动物的检疫工作、加强实验人员的自我防范意识和制定实验动物突发重大事件的应急预案方面阐述了教学实验动物人畜共患病的防控措施.%In order to prevent the infection of zoonoses of animals for teaching and experiment, in this paper the author introduced some common zoonoses with swine, poultry, ruminant, dogs and cats and rats, analyzed factors related with zoonoses. And effective prevention and control measures were proposed from aspects of strengthening base construction for teaching and training, formulating feasible operation specification, strengthening quarantine of laboratory animals, workers' prevention awareness and drafting emergency plans for unexpected events.【期刊名称】《贵州农业科学》【年(卷),期】2012(040)002【总页数】3页(P112-114)【关键词】实验动物;人畜共患病;防控措施【作者】韩庆功;崔艳红;陈金山【作者单位】河南科技学院动物科学学院,河南新乡453003;河南科技学院动物科学学院,河南新乡453003;河南科技学院动物科学学院,河南新乡453003【正文语种】中文【中图分类】S851我国农业高校中的畜牧兽医专业、生命科学专业等相关学科领域中,使用实验动物开展实验教学的范围最广,涉及实验用动物种类最多,所需的实验用动物资源最丰富,主要有大小鼠、兔、鸡、鸭、鹅、鸽、猪、马、牛、羊、犬、猫等,其中,小动物以鸡、兔、鼠为多,此外还有一部分其他种类的原材料,如动物的组织器官、蛋、胚、蛙、鱼、蚯蚓等。